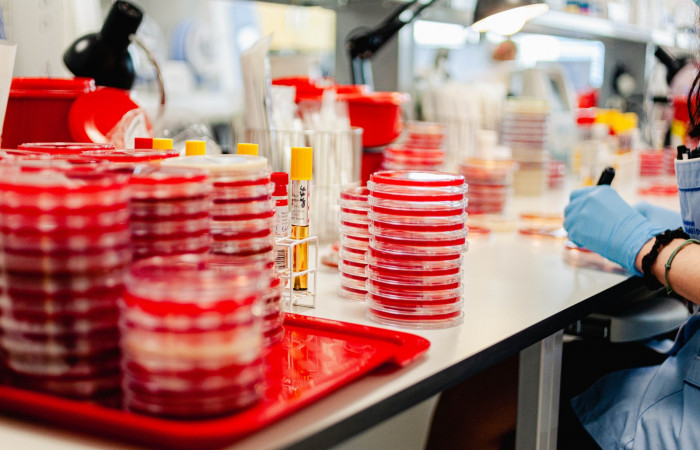
fot. Karolina Fok / Archiwum SU
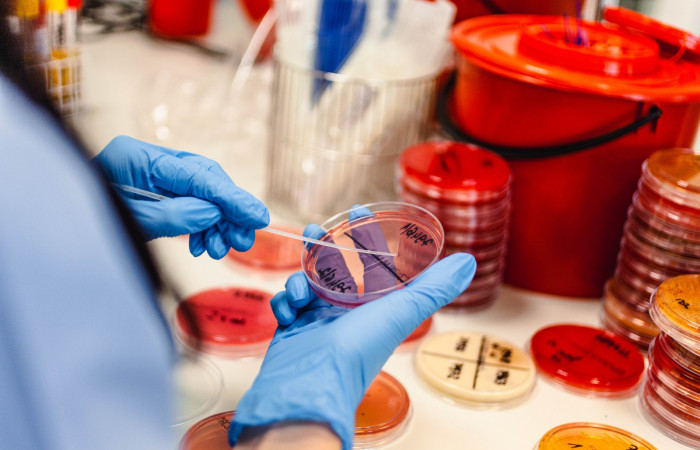
fot. Karolina Fok / Archiwum SU
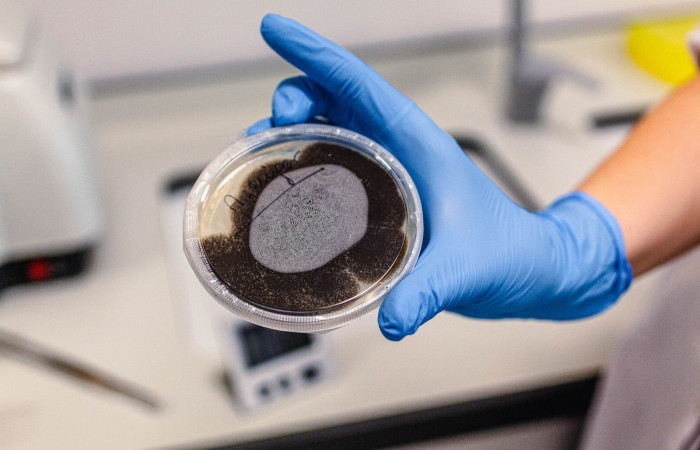
fot. Karolina Fok / Archiwum SU
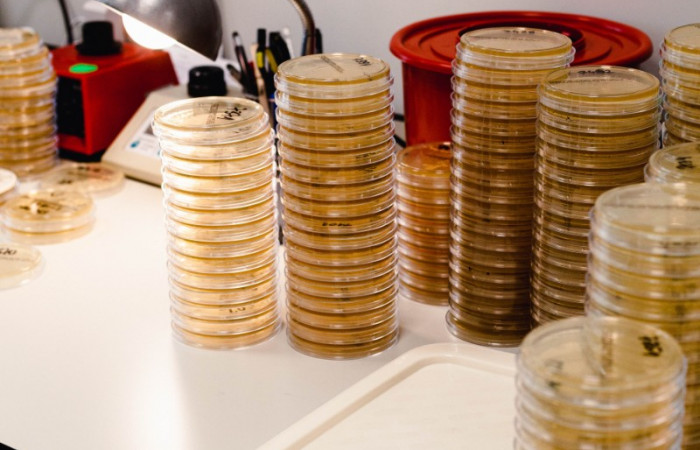
fot. Karolina Fok / Archiwum SU

Wszystkiego co najlepsze, satysfakcji z wykonywanej pracy, spełnienia wszystkich planów i nieustających codziennych radości – tego wszystkiego życzymy naszym drogim Diagnostom Laboratoryjnym w dniu Ich święta.
Dziś - w szczególny sposób - chcemy Wam podziękować za waszą pracę, odpowiedzialność, którą ponosicie podczas wykonywania obowiązków oraz zaangażowanie, które jest niezbędne do prawidłowego rozpoznawania choroby, a potem doboru skutecznego leczenia.
Podglądnijmy wszyscy jak wygląda niezwykle wymagająca, precyzyjna, ale i bardzo ciekawa praca Diagnosty Laboratoryjnego. Zdjęcia zostały wykonane w Zakładzie Diagnostyki, Zakładzie Patomorfologii, Zakładzie Mikrobiologii, Zakładzie Diagnostyki Biochemicznej i Molekularnej, Zakładzie Patomorfologii oraz Zakładzie Diagnostyki Hematologicznej i Genetyki w Nowej Siedzibie Szpitala Uniwersyteckiego.
fot. Karolina Fok / Archiwum SU
fot. Karolina Fok / Archiwum SU
fot. Karolina Fok / Archiwum SU
fot. Karolina Fok / Archiwum SU
fot. Karolina Fok / Archiwum SU
fot. Karolina Fok / Archiwum SU
fot. Karolina Fok / Archiwum SU
fot. Karolina Fok / Archiwum SU
fot. Karolina Fok / Archiwum SU
fot. Karolina Fok / Archiwum SU
fot. Karolina Fok / Archiwum SU
fot. Karolina Fok / Archiwum SU
fot. Karolina Fok / Archiwum SU
fot. Karolina Fok / Archiwum SU
fot. Karolina Fok / Archiwum SU
fot. Karolina Fok / Archiwum SU
fot. Karolina Fok / Archiwum SU
fot. Karolina Fok / Archiwum SU
fot. Karolina Fok / Archiwum SU
fot. Karolina Fok / Archiwum SU
fot. Karolina Fok / Archiwum SU
fot. Karolina Fok / Archiwum SU
fot. Karolina Fok / Archiwum SU
fot. Karolina Fok / Archiwum SU
fot. Karolina Fok / Archiwum SU
fot. Karolina Fok / Archiwum SU
fot. Karolina Fok / Archiwum SU
fot. Karolina Fok / Archiwum SU
fot. Karolina Fok / Archiwum SU
fot. Karolina Fok / Archiwum SU
fot. Karolina Fok / Archiwum SU
fot. Karolina Fok / Archiwum SU
fot. Karolina Fok / Archiwum SU
fot. Karolina Fok / Archiwum SU
fot. Karolina Fok / Archiwum SU
fot. Karolina Fok / Archiwum SU
fot. Karolina Fok / Archiwum SU
fot. Karolina Fok / Archiwum SU